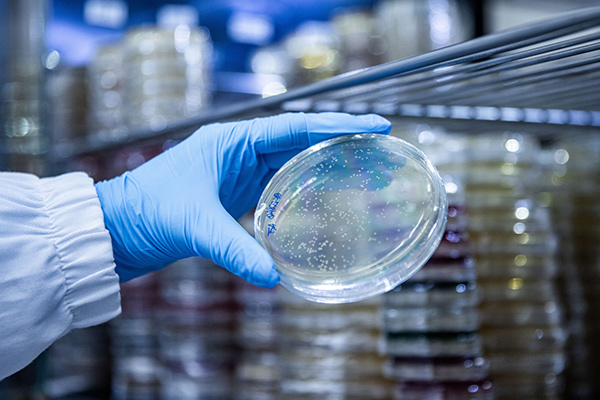
Proprietary strain bank​

We combine technical expertise, practical experience, and a forward-looking vision to transform solutions for personal
care companies.
- Science-Oriented Methodology
- Biotech-Based
- Sustainability Commitment
Get to know Apoena Biocare, the Personal Care brand of Apoena Biotech.

We combine technical expertise, practical experience, and a forward-looking vision to transform solutions for personal
care companies.
Get to know Apoena Biocare, the Personal Care brand of Apoena Biotech.
Our ingredients are developed based on rigorous scientific studies, ensuring safety, efficacy, and functionality. Through applied microbiology and microorganism fermentation, we enhance the natural benefits of biodiversity to provide solutions that meet the demands of the cosmetics market.
In 2021, we established ourselves as Brazil’s first biotechnology industry serving the Cosmetics, Personal Hygiene and Perfumery market.
Extensive collection of native microorganisms, structured and characterized to support continuous development of unique, traceable and high-value bioactive compounds.

Scientific exploration of Brazilian biomes to discover microorganisms and bioactives adapted to extreme conditions, enabling innovative cosmetic ingredient development.

Integrated expertise in microbiology, genomics and biotechnology, ensuring robust research, accurate validation and efficient translation into cosmetic applications.

Bioprospecting conducted under strict environmental and regulatory standards, ensuring responsible use of biodiversity and alignment with global sustainability demands.